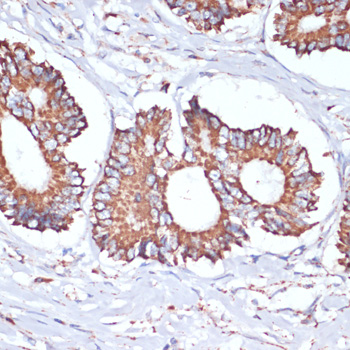
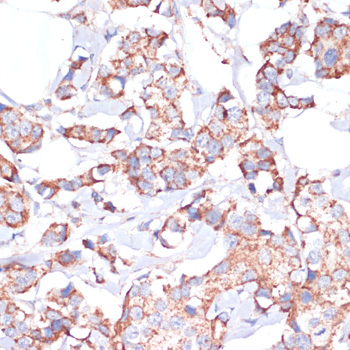

-
Product Name
UBE2O Polyclonal Antibody
- Documents
-
Description
Polyclonal antibody to UBE2O
-
Tested applications
IHC
-
Species reactivity
Human
-
Alternative names
UBE2O antibody; E2-230K antibody; ubiquitin conjugating enzyme E2 O antibody
-
Isotype
Rabbit IgG
-
Preparation
Antigen: Recombinant fusion protein containing a sequence corresponding to amino acids 1073-1292 of human UBE2O (NP_071349.3).
-
Clonality
Polyclonal
-
Formulation
PBS with 0.02% sodium azide, 50% glycerol, pH7.3.
-
Storage instructions
Store at -20℃. Avoid freeze / thaw cycles.
-
Applications
IHC 1:50 - 1:200
-
Validations
Immunohistochemistry - UBE2O Polyclonal Antibody
Immunohistochemistry of paraffin-embedded human colon carcinoma using UBE2O antibody at dilution of 1:100 (40x lens).
Immunohistochemistry - UBE2O Polyclonal Antibody
Immunohistochemistry of paraffin-embedded human breast cancer using UBE2O antibody at dilution of 1:100 (40x lens).

Immunohistochemistry - UBE2O Polyclonal Antibody
Immunohistochemistry of paraffin-embedded human stomach using UBE2O antibody at dilution of 1:100 (40x lens).
-
Background
E2/E3 hybrid ubiquitin-protein ligase that displays both E2 and E3 ligase activities and mediates monoubiquitination of target proteins. Negatively regulates TRAF6-mediated NF-kappa-B activation independently of its E2 activity. Acts as a positive regulator of BMP7 signaling by mediating monoubiquitination of SMAD6, thereby regulating adipogenesis. Mediates monoubiquitination at different sites of the nuclear localization signal (NLS) of BAP1, leading to cytoplasmic retention of BAP1. Also able to monoubiquitinate the NLS of other chromatin-associated proteins, such as INO80 and CXXC1, affecting their subcellular location. Acts as a regulator of retrograde transport by assisting the TRIM27:MAGEL2 E3 ubiquitin ligase complex to mediate 'Lys-63'-linked ubiquitination of WASHC1, leading to promote endosomal F-actin assembly.
Related Products / Services
Please note: All products are "FOR RESEARCH USE ONLY AND ARE NOT INTENDED FOR DIAGNOSTIC OR THERAPEUTIC USE"
